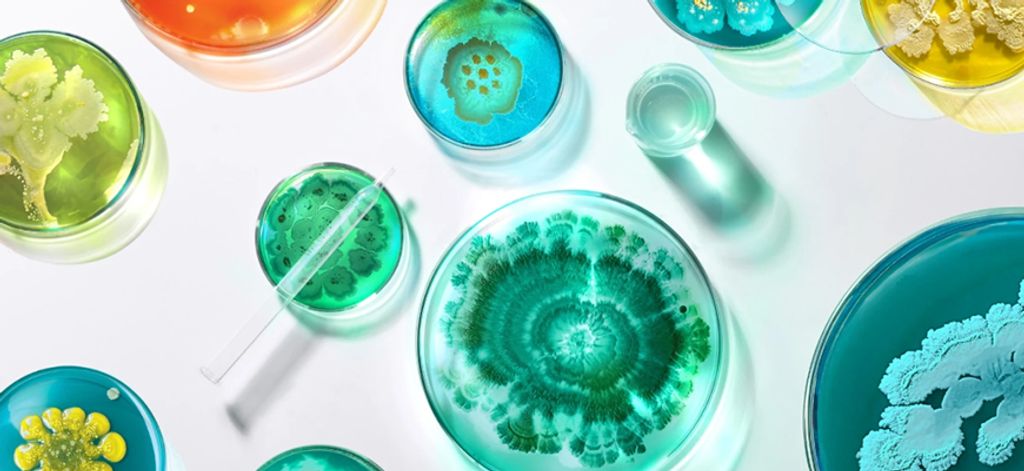
Esse Cover Image

Free delivery for orders over R400. All deliveries are Carbon Neutral
Change the way you shop, for Good. Read our Better Product Policy.

Esse Skincare
Rewild Your Skin
Esse is a South African skincare brand founded and developed by Trevor Steyn, an organic chemist, in Richmond KZN. Trevor’s research began with African plants and their use in cosmetics which led to the formulation of Esse. Over the last 100 years, industrial beauty has disrupted our skin's ecosystem; we pay the price with huge increases in sensitive skin and acne. Esse researches rewilding techniques to restore the skin’s microbiome with probiotics and green chemistry. Esse does not believe in damaging skin in pursuit of short-term results, it optimises skin health to slow ageing in the long-term. It uses prebiotics to feed good microbes and includes LIVE probiotic microbes in two serums to make functional changes to the microbiome. Esse remains true to its principles since inception: its a certified organic, vegan and cruelty free brand that is carbon and plastic neutral, supporting fair trade practices.

Rewild Your Skin
A healthy microbiome is the natural way to keep skin looking youthful. Rewild means to restore your microbiome to its wild and balanced state through green chemistry. Esse creates the environment for your skins natural microbes to flourish and restores it’s ecology. Restore balance and let your skin thrive.

Microbiome Skincare
Esse researches rewilding techniques to restore your skin’s microbiome through organic biotechnology and green chemistry. Probiotics and prebiotics in organic formulations create a skin environment that allows you natural microbial diversity to return and restore balance.

Certified Organic
Esse stays as close to nature as possible and the Ecocert organic standards keep us on track since 2005 in offering sustainable, effective products. We promote organic farming, are against synthetic chemicals, genetic modification and hormone mimics and ensure full traceability of all raw materials.

Sustainability
Esse audits energy consumption yearly and continuously minimises carbon emissions. Esse is plastic neutral by calculating plastic usage, collecting and recycling the equivalent amount. Esse is accredited by The Vegan Society, none of the products are tested on animals and no animal products are used.
Shop by values
Carbon Neutral
Recyclable
Sustainable Palm Oil
Cruelty Free
Vegan
Certified Organic
Certified Organic Ingredients
Fragrance Sensitive
Reef Safe
Proudly South African
Locally Sourced
Fair Production















